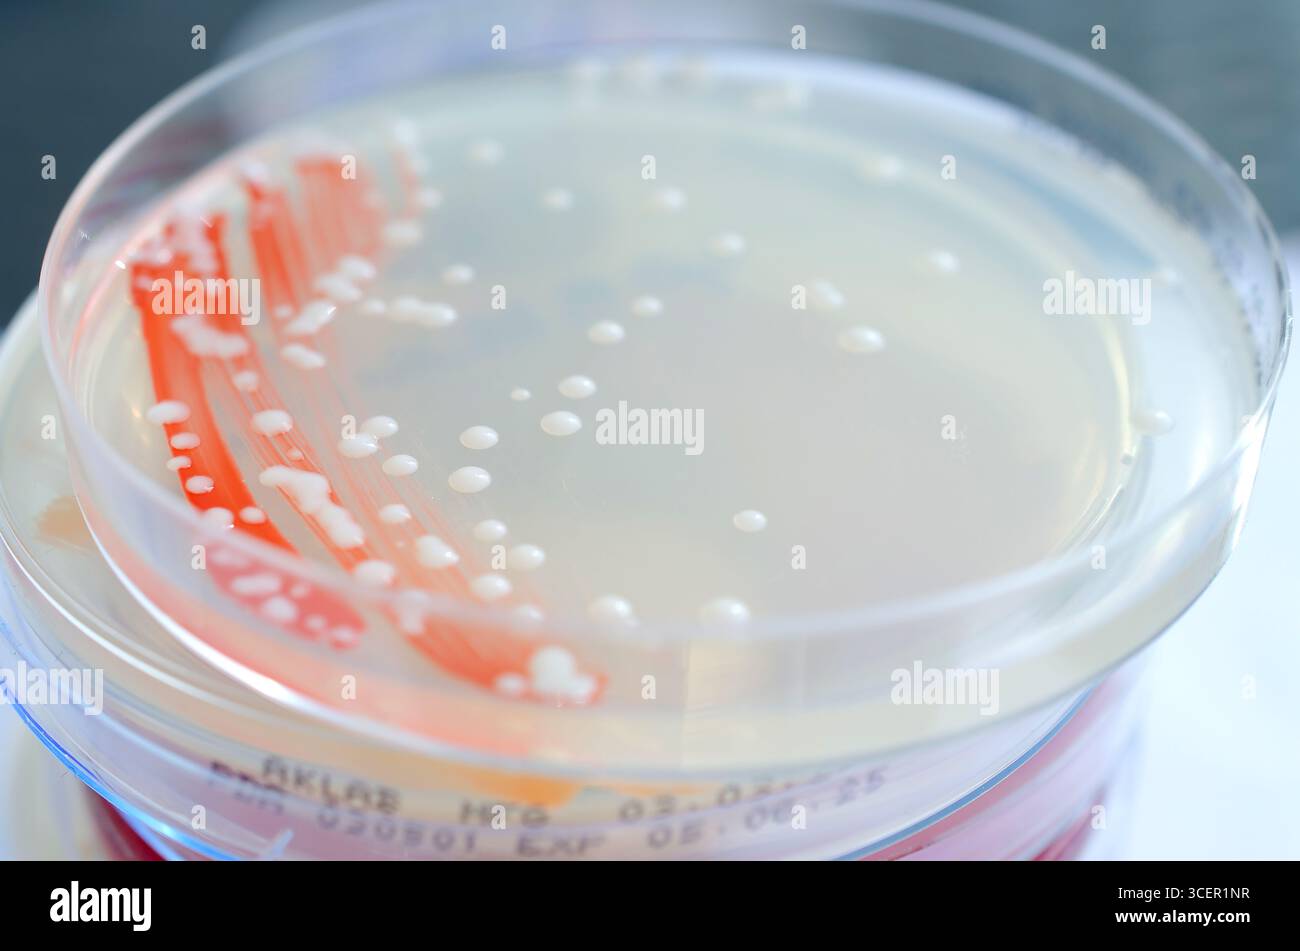
Isolierte Bakterienkolonien auf Kartoffeldextrose-Agar, Foto mit weißen glatten, runden Kolonien mit deckenden Zentren. Stockfoto

Isolierte Bakterienkolonien auf Kartoffeldextrose-Agar, Foto mit weißen glatten, runden Kolonien mit deckenden Zentren.
RFID:Bild-ID:3CER1NR
Bilddetails
Bildanbieter:
Dr_MicrobeBild-ID:
3CER1NRDateigröße:
103,5 MB (1,4 MB Komprimierter Download)Freigaben (Releases):
Model - nein | Eigentum - neinBenötige ich eine Freigabe?Format:
7392 x 4896 px | 62,6 x 41,5 cm | 24,6 x 16,3 inches | 300dpiAufnahmedatum:
30. März 2025